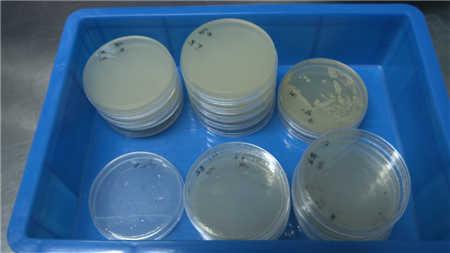
冰箱一年不洗会比马桶还脏 你家的冰箱清洁了吗？
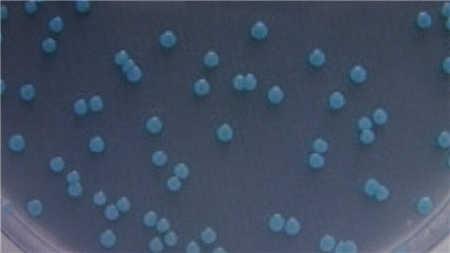
冰箱一年不洗会比马桶还脏 你家的冰箱清洁了吗？

快过年了,大家年货都准备起来了吧。一些保鲜类的蔬菜、禽蛋肉类,大家都会放在冰箱里储藏。但是,您可别以为冰箱就是保鲜箱,冰箱长时间不清理,安全风险不小,听说比马桶还脏哦。
【冰箱一年不洗 会比马桶还脏】
一两年不洗冰箱?那你可得小心咯!全球卫生理事协会在英美等九国做的一项《家庭卫生报告》调查显示,浴室密封胶、冰箱、厨房抹布、水壶柄等日常频繁接触的物体中,冰箱内部污染严重程度排名第二。46%的家庭,冰箱无法通过细菌检测;44%的家庭,冰箱已经有霉菌繁殖扩增迹象。
小钳工家电清洗服务人员表示,冰箱容易滋生细菌的部位,一个夹层的底下,另外一个是盖板的后面。
南京农业大学食品科技学院教授黄明表示,冰箱只是提供了一个温度的环境,但是低温条件下,比如说0到4度,冷藏环境当中,有很多嗜冷菌还在生长。包括导致腐败的,比如说假单胞菌,它能很快增殖。
【致病菌低温繁殖 要小心病从口入】
研究人员从家用冰箱抽屉里搜集样本检测发现,每平方厘米平均含有7850个细菌,有些样本细菌量甚至高达12.9万个。而每平方厘米细菌数在0到10个,才算是清洁安全。进一步临床检测显示,冰箱里主要有沙门氏菌、志贺菌、李斯特菌、耶尔森菌、大肠杆菌和霉菌等等,其中前四种对人影响较大,而单核增生李斯特菌更是被称为冰箱杀手。
黄明教授表示,这种嗜冷菌在低菌量的情况下,就可以发生致病。
【消毒环节很重要 建议每月都清洗】
被这种高致病菌感染,患者会有发烧、怕冷、头疼等症状,病菌会在血液里发挥作用,导致败血症、 脑膜炎等疾病。那么冰箱应该如何保洁呢?
黄明教授表示,用带毛刷的可以去油污,再换一个刷头清理死角。也可以用洗涤剂、温水,把表面有形的污物给除掉。洗完之后,可以用一些消毒液,比如说食用酒精,甚至用一定浓度的二氧化氯的水清洗。清洗完了之后,用清水擦拭,再干燥。水全部蒸发掉后,再把食品放进去制冷。
对于清洗冰箱周期,专家建议,有条件的话最好每月清洗一次。
目前,南京大学的创业团队,正在全南京市开展免费为居民清洗冰箱的活动,如果有这方面需求的居民,可以联系小区物业,通过物业联系小钳工服务平台,原则上小区只要有7户以上,工作人员就可以上门提供免费的清晰服务。
[编后]冰箱里放的鸡蛋,隔一段时间就会散黄,专家表示这就是冰箱需要保洁的信号,因为霉菌破坏蛋白质导致鸡蛋变质了。使用冰箱时,大家要看好物品保质期,过期产品要及时清理掉。当然,最重要的是赶在过年前,赶紧清洗您家的冰箱吧。






公安备案号:32010202010067
我要说两句